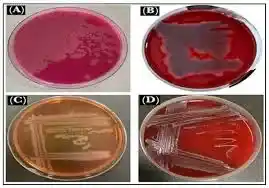
محیط کشت لینکومایسین آگار

محیط کشت لینکومایسین آگار (Lincomycin Agar) یکی از محیطهای کشت اختصاصی در میکروبیولوژی است که بهطور ویژه برای شناسایی و جداسازی باکتریهای حساس به لینکومایسین طراحی شده است. این محیط کشت به دلیل ترکیب شیمیایی خاص خود، برای بررسی مقاومت آنتیبیوتیکی و همچنین رشد انتخابی میکروارگانیسمهای خاص استفاده میشود. در این مقاله، به بررسی جامع این محیط کشت از منظر ترکیب شیمیایی، خواص، کاربردها و روشهای استفاده میپردازیم.
محیط کشت لینکومایسین آگار یکی از محیطهای انتخابی پرکاربرد در آزمایشگاههای میکروبیولوژی و داروسازی است که برای جداسازی و شناسایی گونههای خاص باکتریایی به کار میرود.
این محیط به دلیل وجود آنتیبیوتیک لینکومایسین، توانایی مهار رشد بسیاری از باکتریهای ناخواسته را دارد و امکان رشد انتخابی میکروارگانیسمهای هدف را فراهم میکند. در این مقاله همه چیز درباره این محیط کشت، ویژگیها، کاربردها و روش صحیح استفاده از آن را بررسی میکنیم تا هنگام خرید آگاهانه تصمیم بگیرید.
ما اصالت کالا را تضمین میکنیم. محیط کشت لینکومایسین آگار Merck/Sigma با برگه آنالیز (COA)، بستهبندی استاندارد و مشاوره تخصصی قابل ارائه است. هماکنون سفارش دهید.
برای خرید محیط کشت لینکومایسین آگار با شیمی کهن در ارتباط باشید.
واتساپ:09122885447 ( 24ساعت)
اگر شما یک دانشجو یا پژوهشگر دانشگاهی هستید، میتوانید محیط کشت لینکومایسین آگار را با تضمین اصالت و بستهبندی استاندارد از فروشگاه ما تهیه کنید و پروژه تحقیقاتی خود را با اطمینان پیش ببرید.

لینکومایسین آگار
محیط کشت لینکومایسین آگار (Lincomycin Agar) یک محیط کشت انتخابی در میکروبیولوژی است که برای بررسی حساسیت آنتیبیوتیکی و شناسایی میکروارگانیسمهای حساس به لینکومایسین طراحی شده است. این محیط شامل ترکیبات خاصی است که رشد انتخابی میکروبها را تسهیل میکند و در عین حال، مانع از رشد میکروبهای مقاوم میشود.
لینکومایسین آگار محیطی جامد است که حاوی آنتیبیوتیک لینکومایسین، آگار و مواد مغذی لازم برای رشد انتخابی باکتریهای حساس طراحی شده است. این محیط بهطور ویژه در کشت و جداسازی استرپتوکوکها و سایر باکتریهای گرم مثبت مورد استفاده قرار میگیرد و نقش مهمی در شناسایی گونههای بیماریزا در نمونههای بالینی دارد.

ویژگیها و ترکیب شیمیایی لینکومایسین آگار
- ترکیبات اصلی:
- لینکومایسین: آنتیبیوتیکی که بهعنوان عامل انتخابی برای مهار رشد میکروارگانیسمهای غیرحساس عمل میکند.
- آگار: عامل ژلکننده که بستری جامد برای رشد باکتریها فراهم میکند.
- پپتون و عصارههای غذایی: منبع انرژی و مواد مغذی برای رشد باکتریهای حساس.
- نمکها: برای تنظیم فشار اسمزی محیط.
- ساختار ساده و کارآمد: ترکیب دقیق این محیط، امکان جداسازی میکروارگانیسمهای حساس و بررسی مقاومت آنتیبیوتیکی را فراهم میکند.
- افزودنیهای اختیاری: بسته به نوع آزمایش، میتوان مواد مغذی یا رنگهای خاص به این محیط اضافه کرد.

مشخصات فیزیکو-شیمیایی لینکومایسین آگار
- ظاهر: پودر زرد کمرنگ یا کرمرنگ.
- حلالیت: محلول در آب مقطر (در حالت گرم).
- pH: در محدوده 7.2 تا 7.4 (پس از آمادهسازی).
- دمای انبارداری: 2 تا 8 درجه سانتیگراد.
- پایداری: در برابر حرارت و فشار اتوکلاو مقاوم است.
خواص لینکومایسین آگار
- انتخابی بودن: به دلیل وجود محیط کشت لینکومایسین آگار، این محیط تنها به رشد باکتریهای حساس اجازه میدهد.
- پایداری: ترکیب این محیط در برابر شرایط استریلسازی پایدار است و کیفیت خود را حفظ میکند.
- کاربرد گسترده: برای آزمایشهای حساسیت آنتیبیوتیکی و بررسیهای تحقیقاتی مناسب است.
- سهولت آمادهسازی: دستورالعمل ساده برای تهیه و استفاده.

کاربردهای لینکومایسین آگار
1. در میکروبیولوژی پزشکی:
- بررسی حساسیت آنتیبیوتیکی: محیط کشت لینکومایسین آگار بهطور گسترده در آزمایشگاههای بالینی برای تعیین مقاومت یا حساسیت باکتریها به لینکومایسین استفاده میشود.
- شناسایی پاتوژنهای خاص: مانند Staphylococcus aureus و Clostridium perfringens.
2. در صنعت داروسازی:
- کنترل کیفیت آنتیبیوتیکها.
- تحقیق و توسعه داروهای جدید.
3. در زیستشناسی مولکولی:
- بررسی بیان ژنها و مطالعه مسیرهای متابولیکی با استفاده از باکتریهای حساس به لینکومایسین.
4. در صنایع غذایی:
- شناسایی و بررسی میکروارگانیسمهای بیماریزا در محصولات غذایی.
کاربرد در صنعت شیمیایی
در صنعت شیمیایی، محیط کشت لینکومایسین آگار بهعنوان یک ابزار حیاتی برای تولید محصولات مرتبط با میکروبیولوژی و آنتیبیوتیکها استفاده میشود. برخی کاربردهای مهم عبارتند از:
- تولید آنتیبیوتیکها:
- لینکومایسین آگار برای بررسی اثربخشی داروهای جدید و تولید انبوه لینکومایسین استفاده میشود.
- آنالیز کیفیت محصولات:
- بررسی وجود باکتریهای مقاوم یا حساس در خطوط تولید شیمیایی و دارویی.
- تحقیق و توسعه:
- استفاده در مطالعات بنیادی برای طراحی محیطهای کشت بهینهتر.

ساختار شیمیایی و فرآیند آمادهسازی
ساختار شیمیایی:
- محیط کشت لینکومایسین آگار از پلیساکاریدها (آگار)، آمینواسیدها (پپتون) و لینکومایسین تشکیل شده است. لینکومایسین به عنوان عامل انتخابی عمل میکند و پلیساکاریدهای آگار بستری جامد برای رشد باکتریها فراهم میکنند.
فرآیند آمادهسازی:
- وزنکشی: مقدار مشخصی از پودر محیط کشت لینکومایسین آگار را (طبق دستورالعمل) اندازه بگیرید.
- حل کردن: پودر را در آب مقطر بریزید و بهآرامی هم بزنید تا کاملاً حل شود.
- استریلسازی: محلول را به مدت 15 دقیقه در دمای 121 درجه سانتیگراد در اتوکلاو استریل کنید.
- انتقال: محلول استریلشده را در پتری دیشها بریزید و بگذارید جامد شود.
- ذخیرهسازی: محیطهای جامدشده را در دمای 2 تا 8 درجه سانتیگراد نگهداری کنید.
نحوه استفاده از محیط کشت لینکومایسین آگار
- آمادهسازی محیط:
- پودر لینکومایسین آگار را طبق دستورالعمل کارخانه آماده کنید.
- کشت نمونه:
- نمونه باکتریایی را با استفاده از تکنیکهای استریل روی محیط کشت دهید.
- شرایط انکوباسیون:
- دما: معمولاً 35-37 درجه سانتیگراد.
- زمان: 18-24 ساعت (بسته به نوع باکتری).
- تفسیر نتایج:
- رشد باکتریها نشاندهنده حساسیت به لینکومایسین است.
- عدم رشد نشاندهنده مقاومت میکروارگانیسم.
نتیجهگیری
لینکومایسین آگار با ویژگیهای انتخابی و ترکیب شیمیایی خاص خود، یکی از مهمترین محیطهای کشت در میکروبیولوژی و صنایع دارویی است. این محیط امکان شناسایی و بررسی میکروارگانیسمهای حساس به لینکومایسین را فراهم کرده و در کنترل کیفیت، تحقیق و توسعه داروها، و مطالعات زیستشناسی کاربرد گستردهای دارد. رعایت دستورالعملهای آمادهسازی و استفاده از این محیط، دقت و صحت نتایج آزمایشگاهی را تضمین میکند.
محیط کشت چیست؟
محیط کشت به محیط هایی گفته می شود که بصورت تخصصی برای رشد و تکثیر باکتریها یا سلولها تهیه شده اند و برای این منظور مورد استفاده قرار می گیرند. این محیط ها حاوی مواد خاصی هستند که محیط را برای رشد و تکثیر سلول ها مهیا می کنند.از این مواد می توان به قندها، نمکها، آب و غیره اشاره نمود. جهت خرید محیط کشت می توانید با بخش فروش شرکت شیمی کهن تماس حاصل بفرمایید.

خرید محیط کشت لینکومایسین آگار
شرکت شیمی که نمایندگی سیگماآلدریچ در ایران با همکاری کارشناسان مجرب خود در بخش فنی و فروش جهت تامین مواد اولیه پژوهش های تحقیقاتی ماده با کیفیت بالا و قیمت مناسب را فراهم نموده است. شما می توانید جهت خرید محیط کشت لینکومایسین آگار با بخش فروش شرکت شیمی کهن تماس حاصل بفرمایید و پس از دریافت پیش فاکتور و اطمینان حاصل کردن از صحیح بودن شماره CAS نامبر مواد شیمیایی درخواستی اقدام به ثبت سفارش نمایید تحویل کالاهای خریداری شده و زمان تحویل آنها به صورت زیر می باشد.
ارسال کالاهای موجود در انبار: ۲۴ تا ۴۸ ساعت کاری می باشد.
روش ارسال کالا مشتریان تهران: ارسال توسط پیک
ارسال مشتریان سایر شهرها
توسط شرکت های حمل و نقل ( تیپاکس– پست– ترمینال )

قیمت فروش محیط کشت لینکومایسین آگار
شرکت شیمی کهن یکی از بزرگترین وارد کنندگان و فروشندگان مواد شیمیایی آزمایشگاهی بخصوص فروش محیط کشت لینکومایسین آگار می باشد. این شرکت در زمینه واردات محصولات سیگما از تجربه بسیار بالایی برخوردار است. شما می توانید جهت خرید محصولات نمایندگی مرک آلمان و تهیه این محصول (اصلی) با بخش فروش شرکت تماس گرفته و با کارشناسان این شرکت در ارتباط باشید.
همچنین از طریق کانال واتساپ شرکت نام محصول را به همراه میزان نیاز خود ارسال کنید. در کمترین زمان ممکن پاسخ استعلام خود را دریافت نمائید. امیدواریم بتوانیم با ارائه محصولات اصلی و با بهترین کیفیت شما را برای رسیدن به اهدافتان یاری نمائیم.
جهت محصولات بیشتر در نمایندگی مرک و استعلام سریع قیمت محیط کشت لینکومایسین آگار میتوانید ازطریق کانال واتساپ شرکت با ارسال نام ماده و مقدار نیاز درکمترین زمان پاسخ استعلام خود رادریافت نمائید.
راههای ارتباطی :
021-66895887 (ساعات تماس:8:30 الی 19)
واتساپ:09122885447 (ساعات تماس 24ساعت)